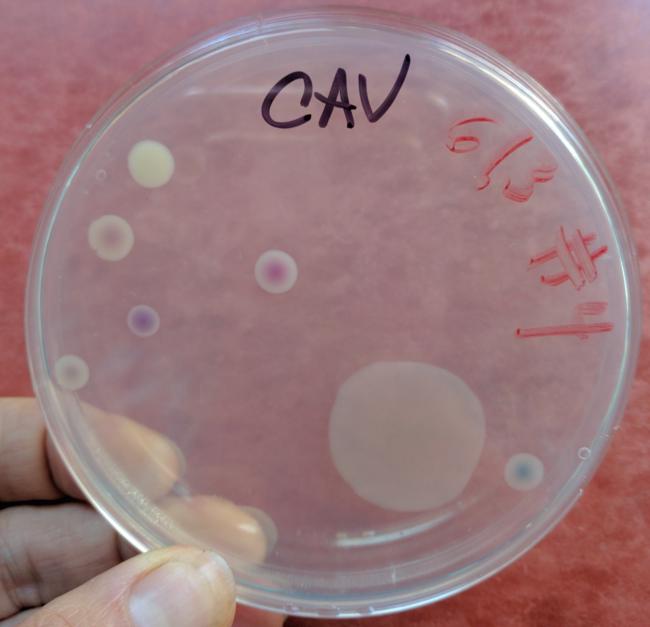

So this morning the email arrived from Omega Biotek that the sequencing data of the beach run were in. It is uploaded to the Illumina Basespace platform, and besides all the raw data files there are also all kind of colorful graphs and numbers for us the non-bioinformaticians to check out.
First thing that jumped at me was that in the day 28 plastic #2 (that is HDPE, and in our case a thin produce bag) the Vibrio counts were high, constituting 2.45% of total reads. We are specifically interested in Vibrios as in the Zettler’s plastisphere article they found high representation of the genus in microplastics. Vibrios are a very diverse group, and include known human pathogens such as Vibrio cholerae and vulnificus, but also animal pathogens and all kinds of environmentally relevant bacteria (including some that can break down plastic).
Just looking at the numbers. seems like the Vibrio counts tend to increase on plastic with time, something that we already saw in the lagoon pilot, although the counts were much lower at that time. The fact is that the highest proportion is for one of the plastic samples the last day of collection brings the usual question: is this is an outlier, error, etc. For now, I will try to suppress my excitement until the data are appropriately crunched and quality checked. Whatever the final results are, it is clear that next time we should increase the sampling time. We have been also discussing the idea of making controlled experiments with seawater in the lab, where it would be easier to monitor what is going on.
Back to the sequencing results, I compared them with the culture results. It is striking to compare the day 28 ChromAgar Vibrio plate of the #2 plastic with the another (#4) plastic. There were tons of Vibrios growing on the plate for #2 (and yes mea culpa, I had no gloves when I took the picture. I won’t do it again, I promise):

And below is #4, which has less colonies. I did not get any colonies for #5, which was strange, and I even thought I had missed swabbing it. Otherwise all plates gave plenty of colonies on salt water agar. So it may be true that we get higher presence of Vibrios on plastic #2. We’ll see.